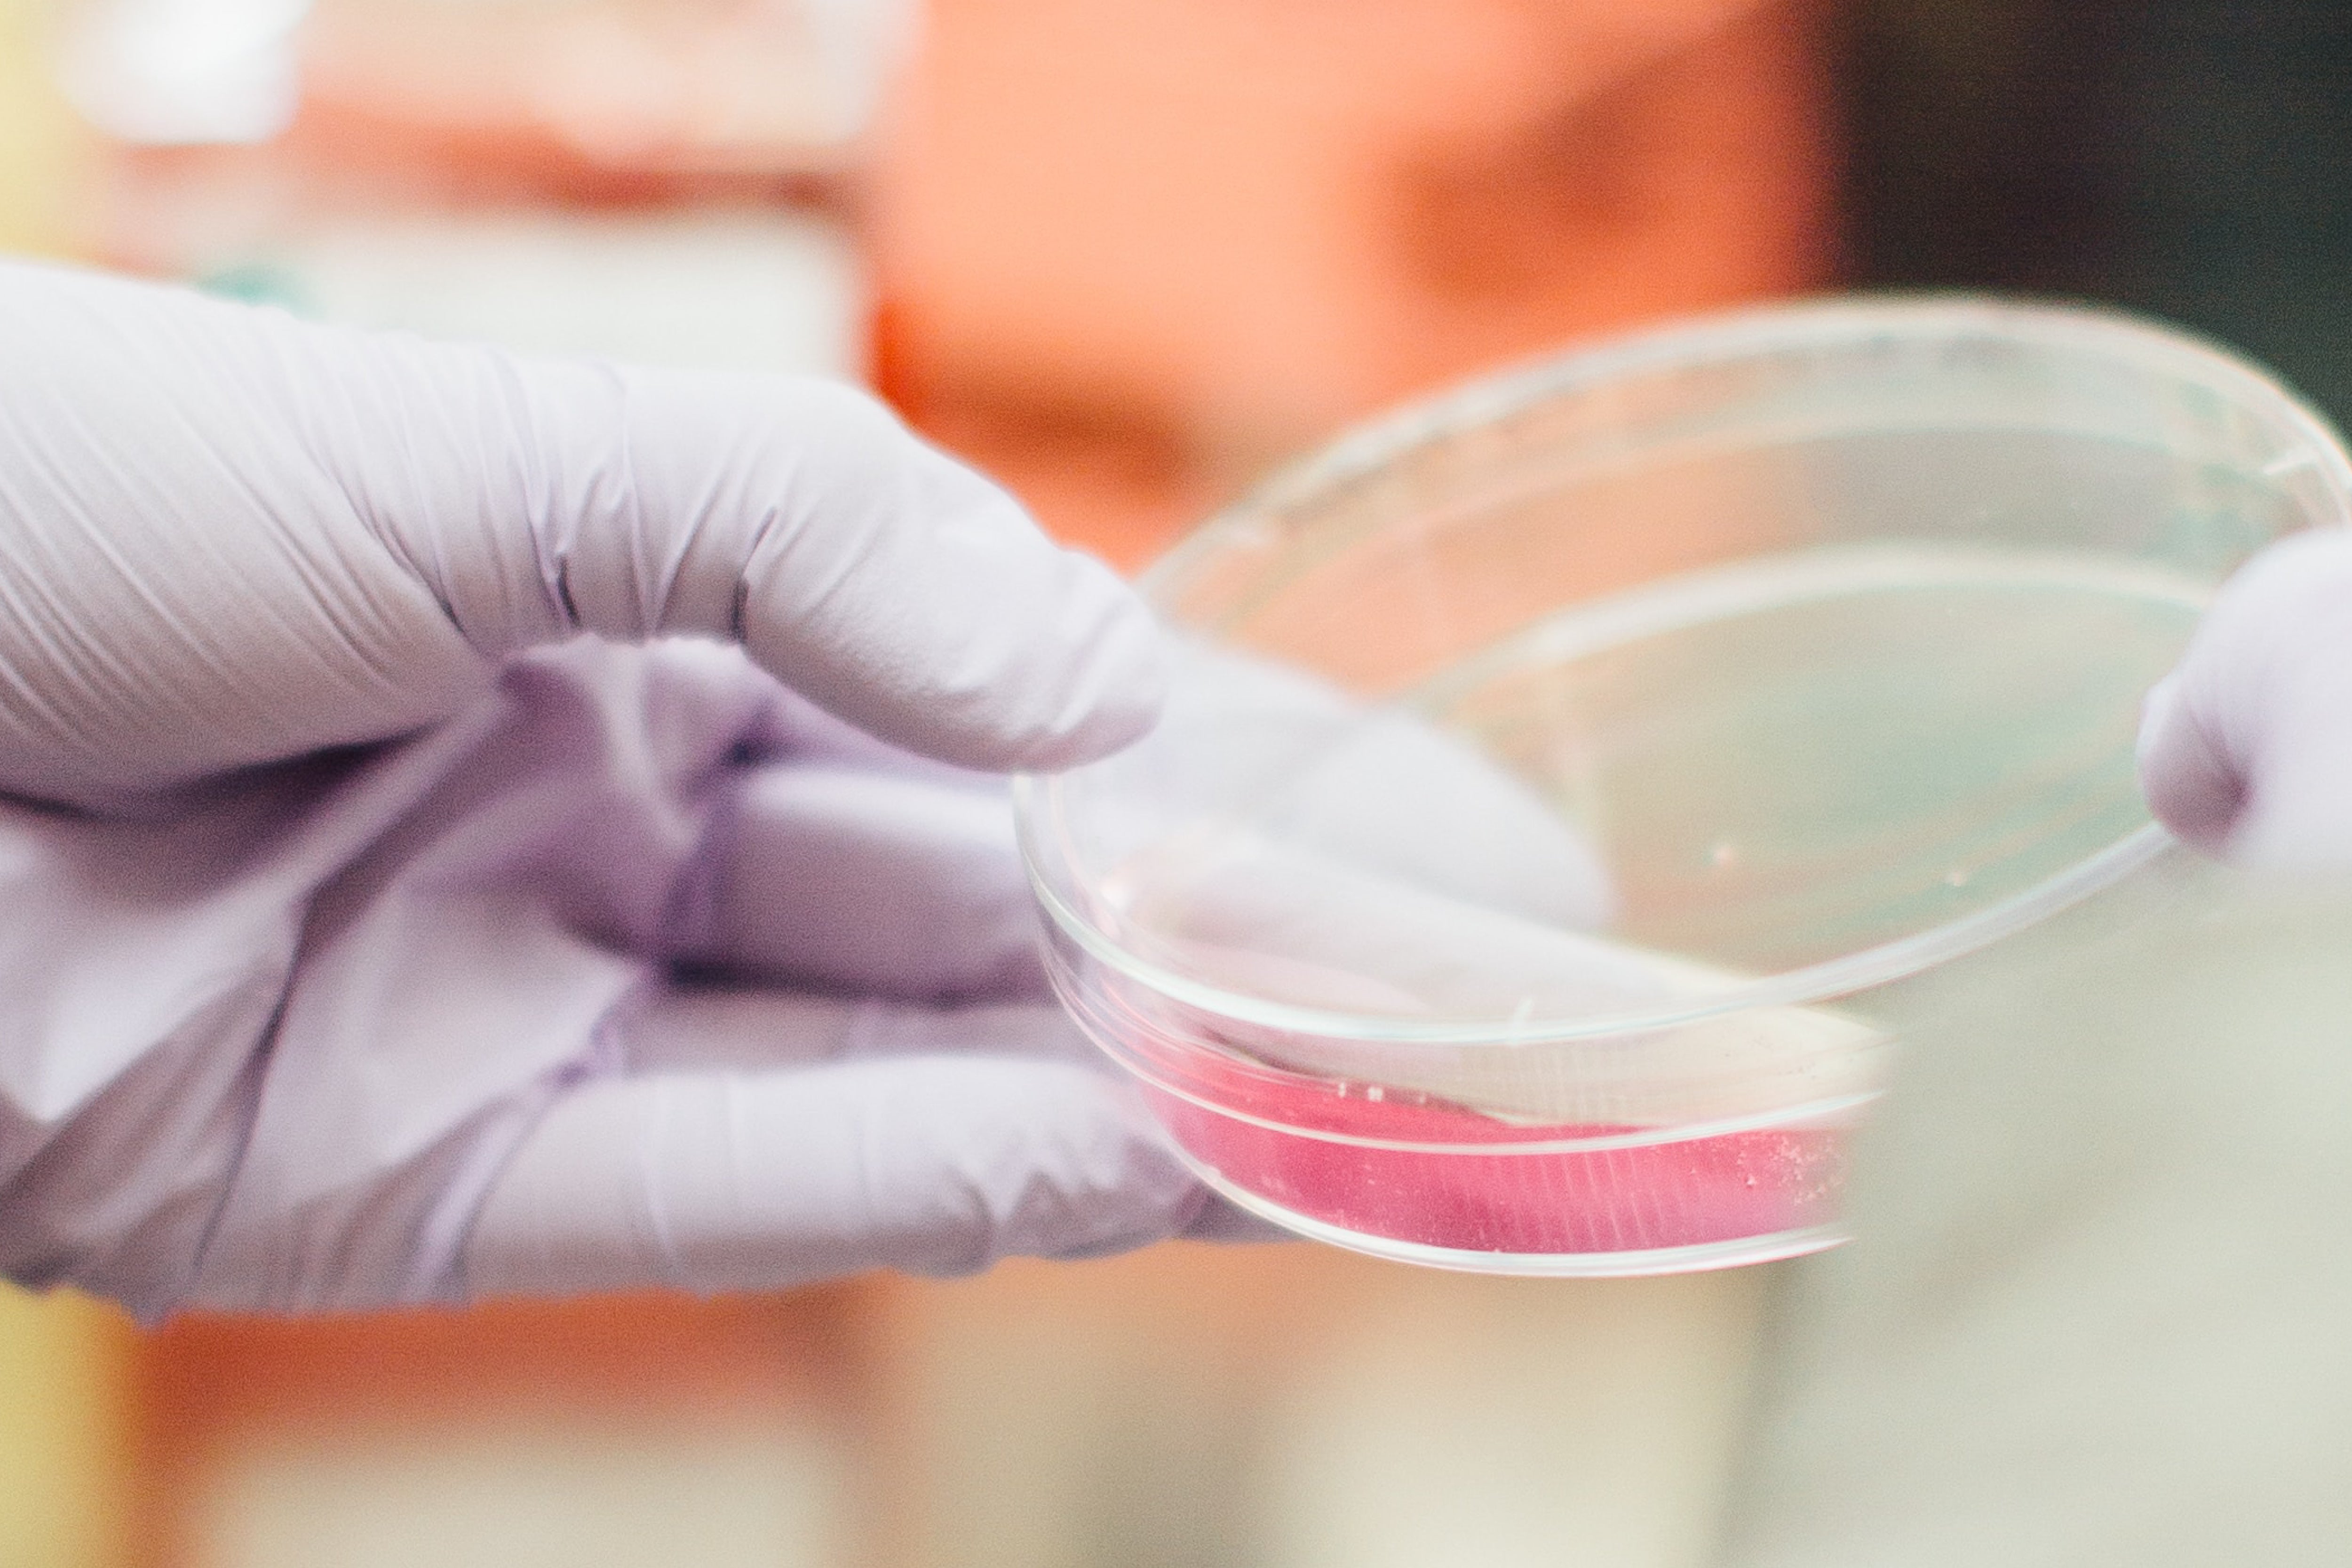

Laborgeprüfte Qualität







Bei ASPRIVA überlassen wir nichts dem Zufall: Jedes unserer Produkte wird in unabhängigen Labors getestet - und zwar jede einzelne Charge. Auch hier orientieren wir uns nicht an dem, was üblich ist, sondern an dem, was wir für richtig halten. Kompromisslose Qualität erfordert kompromisslose Transparenz. Deshalb sind aussagekräftige Laborberichte für uns selbstverständlich. Schließlich geht es um unsere Gesundheit.
Laboranalysen sind wichtig
Selbst in der EU gibt es keine generelle Verpflichtung, Nahrungsergänzungsmittel vor dem Verkauf im Labor auf Reinheit und Unbedenklichkeit zu testen. Systematische Kontrollen? Fehlanzeige. Stichproben zeigen immer wieder gravierende Mängel. Achte deshalb auf vollständige Laboranalysen, sonst ist die Wahrscheinlichkeit groß, dass sich in den Produkten ein paar unerwünschte Überraschungen aus dem Periodensystem für dich befinden. Seriöse Hersteller lassen ihre Produkte daher immer unabhängig testen und veröffentlichen die Ergebnisse für maximale Transparenz. Genauso machen wir das bei ASPRIVA.
Verunreinigungen erkennen, Risiken vermeiden
Leider sind Verunreinigungen in Lebensmitteln heute keine Seltenheit mehr, auch nicht in Bioprodukten. Daher ist es wichtig, den Grad der Kontamination zu bestimmen, um mögliche Gesundheitsrisiken zu minimieren. Zu untersuchen sind Pestizidrückstände, Weichmacher wie Phthalate, Schwermetalle wie Blei, Glyphosat und andere Herbizide, Mykotoxine sowie die mikrobiologische Sicherheit. Nur durch eine umfassende Analyse kann sichergestellt werden, dass ein Produkt unbedenklich verzehrt werden kann.
Umfassende Laboranalysen
Bei ASPRIVA überlassen wir nichts dem Zufall: Jedes unserer Produkte wird in unabhängigen Labors auf Reinheit und Unbedenklichkeit geprüft, und zwar jede Charge aus der Produktion. Warum wir das tun? Weil es dazu als verantwortungs-bewusste Marke einfach keine Alternative gibt. Viele Schadstoffe sind heute leider kaum noch zu vermeiden, die Frage ist nur, wie hoch die Belastung ist.
Daher werden unsere Pulver bspw. auf diese Parameter umfangreich getestet:
→ Pestizidrückstände
→ Weichmacher (z. B. Phthalate)
→ Schwermetalle (z. B. Blei, Quecksilber)
→ Glyphosat und andere Herbizide
→ Mykotoxine (Schimmelpilzgifte)
→ Mikrobiologische Sicherheit

Qualität beginnt im Einkauf
Bei ASPRIVA beginnt Qualität mit der sorgfältigen Auswahl der Rohstoffe. Herkunft, Reinheit und Authentizität werden geprüft, bevor sie verarbeitet werden. Diese unerlässliche Vorarbeit stellt sicher, dass externe Laboranalysen keine bösen Überraschungen bringen. Ohne diesen Aufwand wäre das Ergebnis ein reines Glücksspiel, doch wir setzen auf Kontrolle statt Zufall.

Das letzte Wort hat nicht die Marketingabteilung, sondern unser wissenschaftlicher Beirat.

Die Produktion erfolgt in Deutschland. Es ist uns wichtig, in den Produktionsprozess eng eingebunden zu sein.

Trotz sorgfältiger Rohstoffauswahl sind Labortests unerlässlich, um Reinheit, Sicherheit und Qualität zu garantieren.
Häufig gestellte Fragen
Alle Laborberichte zu den Produkten findest du bei jedem Produkt im Shop oben rechts unter dem Reiter "Laboranalyse", dort findest du auch die aktuellen PDFs.
Bei unserem VITAQ OMEGA3 1100 wurde ein breites Spektrum an Qualitätsparametern in unabhängigen Labors geprüft, um sicherzustellen, dass eine regelmäßige Einnahme im Rahmen deiner Longevity-Routine risikofrei möglich ist. Dazu gehören Schwermetalle, mikrobiologische Sicherheit, Dioxine und PCB sowie Frische/Oxidation. Zudem wurde der effektive Omega-3-Gehalt pro Kapsel ermittelt.
Unsere wasserlöslichen ASPRIVA-Pulver enthalten pflanzliche und natürliche Extrakte, keine rein synthetischen Inhaltsstoffe. Daher ist ein umfassendes Spektrum an Tests zwingend erforderlich. Unabhängige Labore prüfen sie auf Schwermetalle (Blei, Cadmium, Quecksilber, Arsen), Dioxine & PCB (industrielle Schadstoffe), Pestizide (chemische Rückstände aus der Landwirtschaft), Weichmacher (Phthalate) aus Verpackungen, Glyphosat (häufig verwendetes Pestizid), Mykotoxine (Schimmelpilzgifte) sowie mikrobiologische Sicherheit (Keime, Hefen, Schimmel). Diese Analysen gewährleisten eine sichere und bedenkenlose regelmäßige Einnahme.
Pflanzenextrakte enthalten natürliche Verbindungen, die Verunreinigungen aus Anbau, Verarbeitung und Lagerung aufnehmen können. Daher sind mehr Tests nötig. Auch Rohstoffe in Bio-Qualität sind betroffen, da sie durch Böden, Luft oder Verarbeitung mit Schwermetallen, Mykotoxinen oder Weichmachern belastet sein können. Neben Schwermetallen und Keimen müssen sie auf Pestizide, Weichmacher (z. B. aus Verpackungen), Glyphosat, Mykotoxine (Schimmelpilzgifte) und Dioxine & PCB (industrielle Schadstoffe) geprüft werden, um Sicherheit und Reinheit zu gewährleisten.